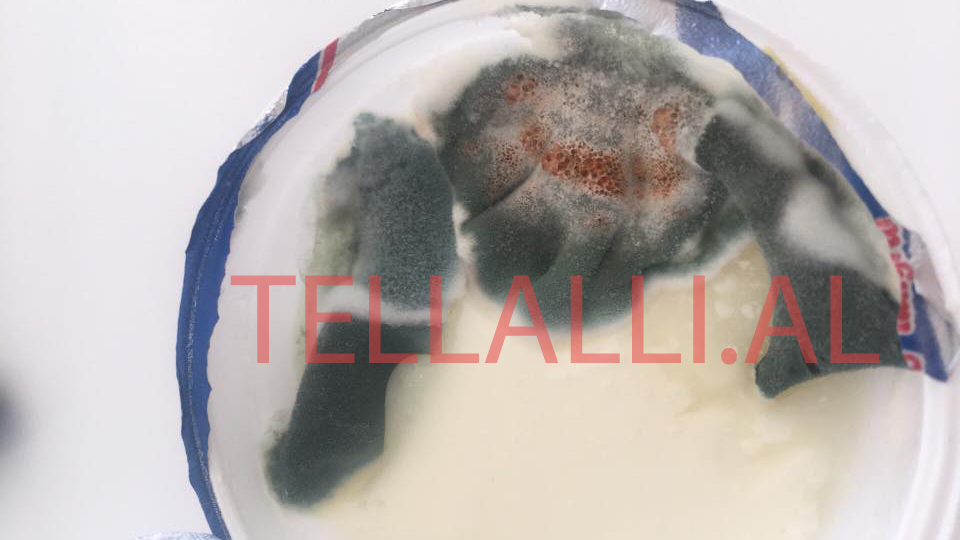
Produktet ‘Erzeni’ me vaj palme, niseshte dhe qumësht pluhur; AKU pjesë e krimit kundër njerëzve Produktet ‘Erzeni’ me vaj palme, niseshte dhe qumësht pluhur; AKU pjesë e krimit kundër njerëzve

Jo vetëm mbi 1 ton qumësht pluhur, por çdo vit futen në Shqipëri qindra ton niseshte, vaj palme, xhelatinë dhe lloj-lloj kimikatesh të rrezikshme, të cilat më pas përzihen me qumështin dhe nënproduktet e tij nga kompanitë mafioze të përpunimit të qumështit.
Veprimtaria kriminale me pasoja të rënda dhe ndoshta fatale në jetën e qytetarëve konsiston në faktin se produktet e bulmetit me kimikate paraqiten me etike si produkte 100 % natyrale, pra bio që vijnë drejtpërdrejtë gjoja nga qumështi i freskët i lopës, deles dhe dhisë.
Ndërsa numri i lopëve dhe bagëtive të imta sa vjen e bie çdo vit, nga ana tjetër sasia e qumështit dhe nënprodukteve të tij sa vjen e rritet. Pyetja e thjeshtë dhe natyrshme është: Ku e marrin këto kompani qumështin që shtojnë vit pas vitit kur numri i lopëve bie?
Mes kompanive kriminale, të cilat hedhin vaj palme, niseshte, qumësht pluhur, xhelatinë etj., në nënproduktet e qumështit është edhe kompania ‘Erzeni’, e cila kontrollohet nga klani familjar Isuf, Ridvan, Erzen, Mitat, Saimir dhe Renato Begaj.
Prokuroria dhe SPAK e kanë tejet të lehtë për të dokumentuar krimin e klanit ‘Erzeni’, duke marrë informacion nga doganat për kimikatet që kompania ka futur në Shqipëri, duke ushtruar kontrolle në fabrikën ‘Erzeni’ si dhe duke analizuar në laboratorë produktet e kësaj kompanie që ka hedhur në treg.
Në vijim do të japim detaje rreth këtij krimi masiv kundër njerëzimit, ku të përfshirë janë kompania ‘Erzeni’, por edhe kompani të tjera të njohura në vend, të cilët të gjitha bashkë korruptuan segmente të qeverisë dhe Komisionin e Ekonomisë për të tërhequr taksën e propozuar 100 lekë për kilogram për qumështin pluhur.
Të gjitha kompanitë kryesore të përpunimit të qumështit dhe nënprodukteve të të tij, i deklarojnë produktet si natyrale. Por, kur Ministria e Financave propozoi taksën 100 lekë për qumështin pluhur, këto kompani u bashkuan duke kundërshtuar ashpër propozimin. Nga disa mbledhje të mbajtura sekret, u zbulua se kompanitë fusnin në Shqipëri mbi 1 ton qumësht në vit, pa llogaritur sasinë që futet kontrabandë.
Çfarë e bëjnë këto kompani qumështin pluhur kur produktet i paraqesin në etiketë si bio? E hanë vetë 1 mijë ton qumësht pluhur?! Sigurisht që e përziejnë. Pra, ulja e numrit të lopëve dhe futja e qumështit pluhur në dogana janë dy fakte që konfirmojnë krimin e masiv kundër shëndetit të popullatës në Shqipëri.
Nga ana tjetër, qumështi pluhur nuk është i vetmi që përzihet me qumështin, kosin, djathin, gjalpin, gjizën etj. Nga një dosje që disponojmë me fakte dhe prova, në dogana kanë hyrë me qindra ton vaj palme, niseshte dhe xhelatinë, pa u kontrolluar nga AKU se ku ka përfunduar.
AKU është në fakt koka e mafies së qumështit në Shqipëri, pasi lejon këtë aktivitet kriminal me pasoja të rënda. Pothuajse të gjithë krerët e AKU janë kallëzuar në prokurori si pjesë e krimit, por ende nuk janë ndëshkuar. Dy muaj më parë, Kontrolli i Lartë i Shtetit kallëzoi në prokurori kreun e AKU, Bledar Skënderi, tashmë i shkarkuar, pasi ka lejuar futjen dhe konsumimin e 36 ton akullore me lëndë të rrezikshme dhe të ndaluara. Por edhe drejtoresha e re e AKU-së nuk se ka dhënë ndonjë shenjë apo reagim/Pamfleti